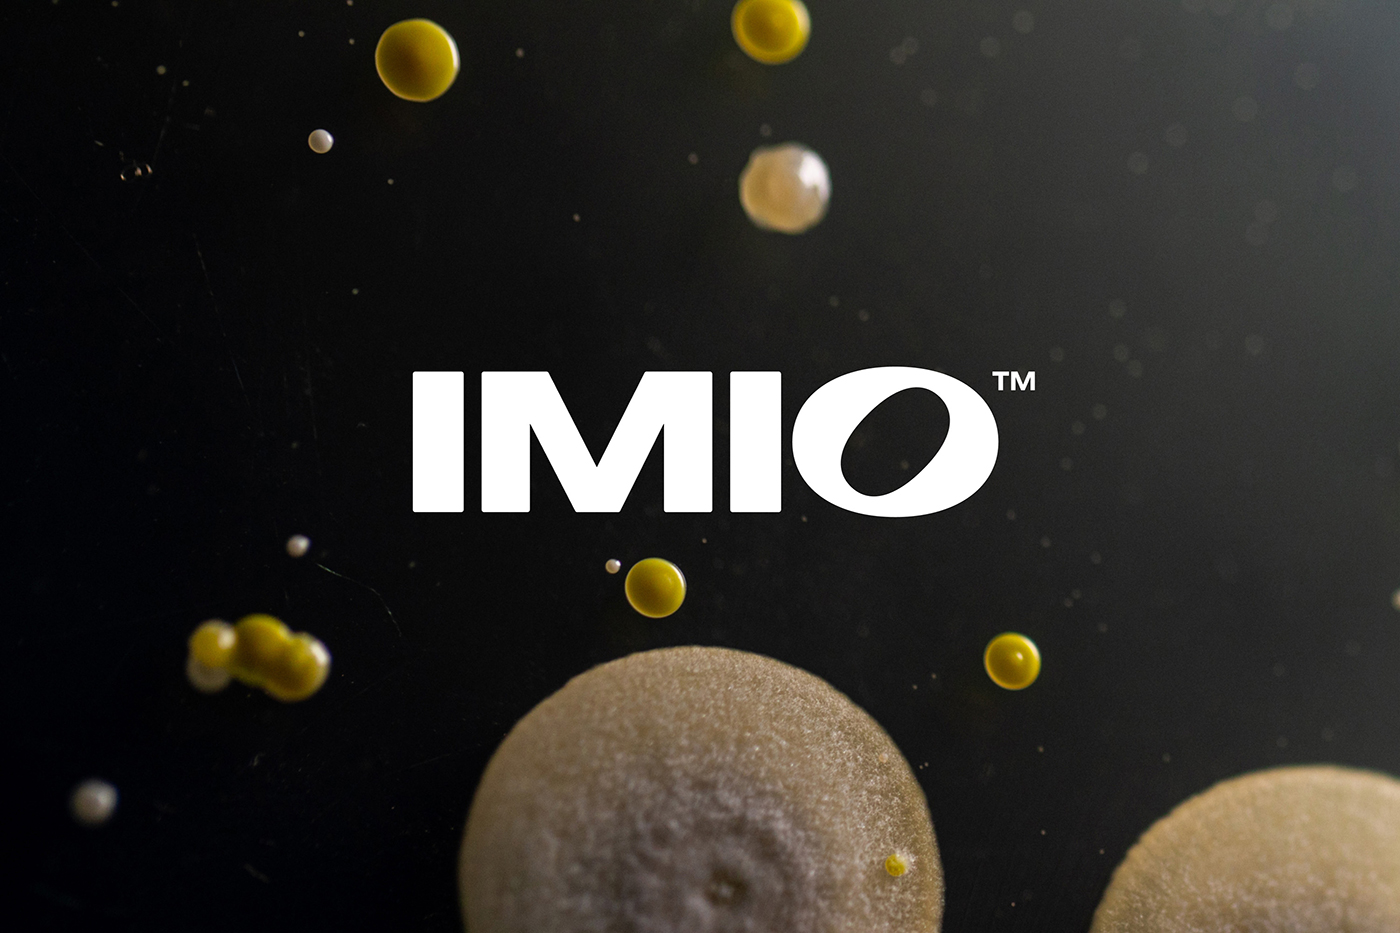

在绿色农业科技迅猛发展的今天,一个出色的企业形象设计是新技术品牌成功进入市场、建立用户认知的关键。本文将通过创新农业品牌Imio的完整品牌创建案例,深度解析其企业形象设计如何巧妙融合自然灵感与科学精神,成功构建出一个极具辨识度且承载品牌使命的视觉系统。
项目背景
Imio是一家肩负使命的农业科技公司,旨在通过利用活性微生物的智能,释放更大的农业生产力并修复地球。公司的全天然微生物接种剂,使农民能够在不依赖农药的情况下,种植出更健康、更高产的作物。在历经多年的研发与临床研究后,品牌需要一个能够支撑其直接面向消费者的电商体验、并适用于所有触点的企业形象设计。
公司简介
Imio不仅是一个产品,更是一场农业革命。它站在自然与科学的交汇点,通过颠覆性的生物技术,为可持续农业提供了全新的解决方案,致力于重塑现代农业的生产方式。
设计理念
本次企业形象设计的核心理念是“让自然与科学协同工作”。设计团队旨在创建一个既现代又有机的视觉系统,完美呼应Imio品牌本身融合尖端科技与自然力量的独特属性。整个VI设计(视觉识别设计)都在探寻田野与实验室之间的美学平衡。
视觉形象与Logo设计
在Logo设计上,团队将简洁的无衬线字体与自然的线条形态相融合,创造出独具一格的品牌字标。这种设计既保留了科技公司所需的现代与严谨,又注入了有机、生长的自然气息,形成了“自然与科学共生”的视觉隐喻,这正是高水平品牌形象设计的体现。
识别颜色与核心价值
色彩与影像系统同样遵循这一理念,色彩游走于田野的生机与实验室的纯粹之间。品牌的核心价值是“创新、自然、可信与赋能”。其完整的企业形象设计系统确保了这些抽象价值能通过具体的视觉语言,清晰、一致地传递给农民、合作伙伴及所有受众。
品牌定位与使命愿景
- 品牌定位:领先的天然农业微生物解决方案提供者,连接科学与土地的创新桥梁。
- 使命:通过 harnessing 活性微生物的智能,解锁农业生产力,促进地球生态恢复。
- 愿景:成为全球农业绿色转型的核心推动者,构建一个免于化学农药的农耕未来。
宣传语与受众分析
品牌宣传语可紧扣其技术特性,例如:“自然的智慧,科学的馈赠”。其目标受众主要为:寻求可持续种植方式的现代农民、注重农产品安全与品质的农业合作社、以及关注环境效益与科技创新的农业投资机构。
设计师/设计公司介绍
这一卓越的企业形象设计项目由G—W Studios设计工作室操刀。该团队擅长为科技创新品牌构建深具策略性的视觉身份,其作品以清晰的概念和强烈的视觉表现力著称,能够帮助像Imio这样的新兴品牌在传统行业中建立强大的差异化优势。
文章小结
Imio的品牌案例充分证明,一套策略精准的企业形象设计能够为农业科技这类B2B属性较强的品牌注入强大的市场沟通力。它成功地将“微生物技术”这一不易感知的科学概念,转化为一套和谐融合“田野与实验室”美学的视觉系统。这不仅是VI设计的胜利,更是战略性品牌构建的典范——它让Imio在农业领域众多品牌中脱颖而出,为其独特的DTC电商模式奠定了坚实的品牌基础,也为所有科技驱动型品牌如何面向市场提供了宝贵的企业形象设计经验。












